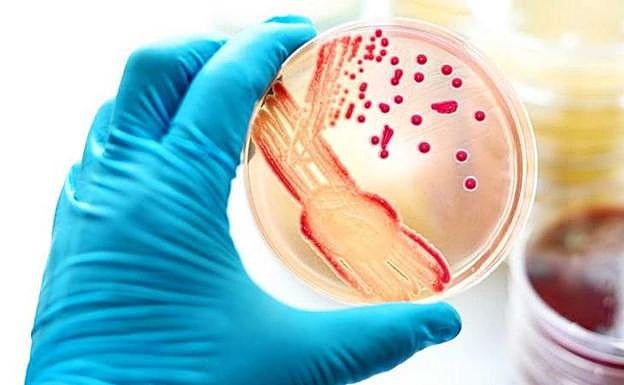
La gonorrea se multiplica en Europa

La gonorrea se multiplica en Europa
Se diagnostican más de 240 casos al día de esta enfermedad de transmisión sexual
ep
Lunes, 29 de abril 2019, 15:06
Tras un descenso de las notificaciones en 2016, el número de casos de gonorrea ha aumentado un 17 por ciento en los países de la ... Unión Europea (UE) y del Espacio Económico Europeo (EEE), con más de 89.000 diagnósticos confirmados en 2017, es decir, más de 240 al día, según datos del Centro Europeo para la Prevención y Control de Enfermedades (ECDC, por sus siglas en inglés).
El aumento en 2017 continúa con la tendencia general de la última década, en la que 20 de los 28 países de la UE/EEE que han registrado datos han experimentado un aumento del número de casos de gonorrea. Desde 2008, en Francia y Portugal los casos se han multiplicado por seis, mientras que Dinamarca e Irlanda registran actualmente más del triple de casos confirmados.
Tras un pequeño descenso en 2016, las notificaciones de gonorrea volvieron a aumentar en la mayoría de los 27 países que presentaron informes en 2017. Algunos países registraron notables aumentos interanuales de más del 40 por ciento, como Finlandia y Suecia. Con 558.155 casos confirmados entre 2008 y 2017, la gonorrea es la segunda infección de transmisión sexual más notificada en la UE/EEE después de la clamidia (más de 3,8 millones de casos notificados durante el mismo período).
Los hombres que tienen sexo con hombres (HSH) representaron casi la mitad de los casos de gonorrea (47%) en 2017
Los hombres que tienen sexo con hombres (HSH) representaron casi la mitad de los casos de gonorrea (47%) en 2017. El aumento de los casos notificados entre 2016 y 2017 (de 9,5 a 11 por cada 100.000 habitantes) es «preocupante», ya que «la gonorrea no tratada puede provocar enfermedad inflamatoria pélvica o causar infertilidad», advierte el organismo europeo.
En consecuencia, las tasas de infección por gonorrea varían considerablemente en toda Europa, desde menos de 1 a 75 casos por cada 100.000 habitantes, y las tasas son más elevadas en el norte de Europa. Aunque esta variación podría estar relacionada con diferencias reales en la incidencia de la infección gonocócica, es probable que estén influenciadas por diferentes políticas y métodos de pruebas, sistemas de atención sanitaria y acceso a los servicios, así como estructuras de sistemas de notificación y vigilancia.
«La gente sigue teniendo relaciones sexuales con parejas nuevas y ocasionales sin condones, lo que facilita la transmisión de una infección que es cada vez más resistente a las opciones comunes de tratamiento con antibióticos. Si estás en riesgo, asegúrate de hacerte la prueba regularmente. Debemos tener en cuenta que las cifras que vemos ni siquiera muestran la verdadera magnitud de la epidemia de gonorrea en Europa. Muchas infecciones no son diagnosticadas debido a la falta de síntomas o al acceso limitado al diagnóstico o simplemente no son reportadas», destaca el experto de ECDC Gianfranco Spiteri.
A principios de este año, los resultados del Programa de Vigilancia Antimicrobiana Gonocócica Europea del ECDC mostraron un nivel persistente de resistencia de 'Neisseria gonorrhoeae' a la azitromicina, que compromete la terapia dual recomendada con ceftriaxona y azitromicina.
¿Tienes una suscripción? Inicia sesión